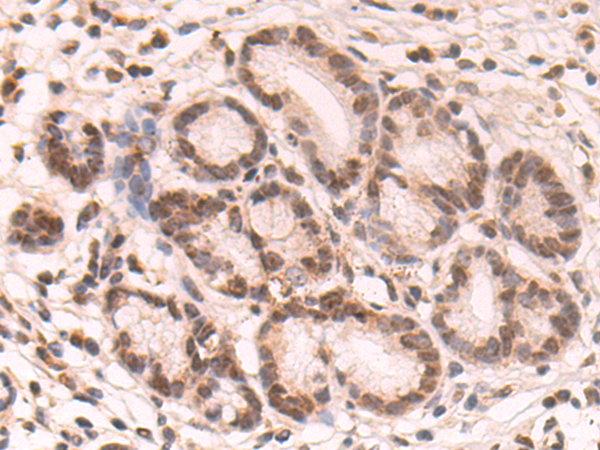
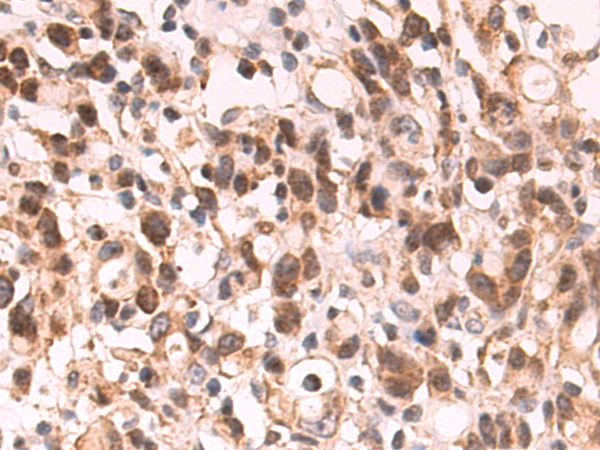

-
分类: 科研抗体货号: P09106别名: TEX6; ZR14; HTEX6; Rpa12; hZR14; HTEX-6; TCTEX6; tctex-6应用: IHC反应种属: Human, Mouse, Rat
-
分类: 科研抗体货号: P09105别名: Acrg应用: IHC反应种属: Human, Mouse
-
分类: 科研抗体货号: P09122别名: UGPP; UGPPase应用: IHC反应种属: Human, Mouse
-
分类: 科研抗体货号: P09104别名: INDOL1应用: WB,IHC反应种属: Human
-
分类: 科研抗体货号: P09144别名: LAMP; IGLON3应用: WB,IHC反应种属: Human, Mouse, Rat
-
分类: 科研抗体货号: P09121别名: APS2; DIPP3a; DIPP3-alpha应用: WB,IHC反应种属: Human, Mouse
-
分类: 科研抗体货号: P09136别名: D12; P31; SLT1; MDS032应用: WB,IHC反应种属: Human, Mouse
-
分类: 科研抗体货号: P09143别名: 2DD; HUM2DD应用: IHC反应种属: Human
-
分类: 科研抗体货号: P09120别名:应用: WB,IHC反应种属: Human, Mouse
-
分类: 科研抗体货号: P09135别名: B17.2; DAP13应用: WB,IHC反应种属: Human, Mouse

鄂公网安备42018502007531号
鄂公网安备42018502007531号

